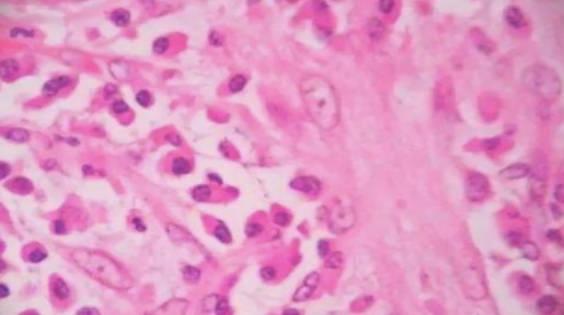

導讀 肉芽組織是皮膚表面的創傷處或者是切口的地方出現的新生薄壁毛細管神經和纖維細胞組織,洛陽的顏色是鮮紅色的,形狀呈顆粒狀。
肉芽組織是皮膚表面的創傷處或者是切口的地方出現的新生薄壁毛細管神經和纖維細胞組織,洛陽的顏色是鮮紅色的,形狀呈顆粒狀,由于外形和肉芽極其相似,所以被叫肉芽組織,肉芽組織也能被稱之為幼稚階段的纖維芥蒂組織,其中的主要成分有炎性細胞成纖維細胞和較細的血管組成。
肉芽的功能,主要就是對身體的傷口進行填充和修復,當身體內被刺入異物的時候,身體的自愈能力就會產生肉芽組織,這些新生的肉芽組織會將異物逐漸的推出去,傷口在修復的過程中就會有新鮮的肉芽組織逐漸的生長,同時還會伴隨著滲出炎性細胞,這些炎性細胞主要是巨噬細胞,聚酯細胞具有抗感染的功能,能夠分泌一種抗感染和修復傷口的物質,這些物質能夠刺激新生的纖維母細胞和毛細血管增生。
肉芽組織中包含的毛細血管,內皮細胞也具有吞噬功能,還具有超強的溶解纖維蛋白的作用,能夠將傷口在生長過程中產生的細菌都吞噬掉,還可以吞噬掉一些碎組織,再將這些細胞和碎組織都破壞掉以后,還會釋放出一種叫做蛋白水解酶的物質,這個物質能夠加快傷口的修復。
當這里有創傷,2~3天的時候,就會出現肉芽組織,肉芽組織清楚不疼,但是很容易出血,這是因為肉芽組織含有水腫液,這些水溶液中并沒有神經纖維,所以不會疼痛,隨著時間的加長肉芽組織會逐漸成熟,主要表現為肉眼組織內的水分逐漸減少,毛細血管數量也開始減少,成纖維細胞,在這個時候就會產生大量的膠原蛋白,這種肉芽組織會轉變成為纖維細胞,從而形成疤痕。